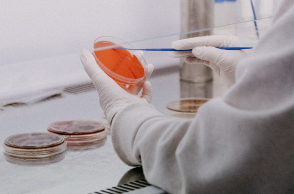
Ιατρικό εργαστήριο

- CITY GUIDE
- PODCAST
-
 17°
17°
Ποια είναι τα μυστικά για ένα όμορφο πρόσωπο
Μεταξύ 40 και 45 οι πρώτες αλλαγές στο πρόσωπο


Τι μπορούμε να κάνουμε για να καθυστερήσουμε τη γήρανση στο πρόσωπό μας
Αλλαγές στην εμφάνισή μας προκαλεί ο χρόνος που περνάει, ειδικά στο πρόσωπο μας, καθώς αποτυπώνεται κάθε χαρά και στεναχώρια με αποτέλεσμα να γίνεται ο «χάρτης» των όσων έχουμε ζήσει, κατά τη διάρκεια της ζωής μας, Η ηλικία μεταξύ 40-45 ετών είναι αυτή κατά την οποία, συνήθως, παρατηρούνται αλλαγές στο πρόσωπο, καθώς και τα πρώτα σημάδια γήρανσης, τα οποία είναι:
Χαλάρωση: «κρέμασμα» του προσώπου λόγω της απώλειας της ελαστικότητας του δέρματος και της μετακίνησης (με τη συμβολή της βαρύτητας) του υποδόριου λίπους προς τα κάτω.
Έκπτωση του όγκου: «άδειασμα» του προσώπου και κατά συνέπεια δημιουργία ρυτίδων στο μέτωπο, στις γωνίες των ματιών («πόδι της χήνας») ή των χειλιών και βάθυνση των ρυτίδων έκφρασης.
Φωτογήρανση: «στεγνό», αφυδατωμένο δέρμα, εμφάνιση αραχνοειδών φλεβών στη μύτη, στα μάγουλα και στο λαιμό ή/και καφέ ή κόκκινες κηλίδες.
«Η διαδεδομένη αντίληψη ότι τα σημάδια αυτά εμφανίζονται λόγω της γήρανσης είναι εν μέρει σωστή, καθώς η πραγματικότητα είναι λίγο πιο σύνθετη. Τα σημάδια της γήρανσης εμφανίζονται όταν μεγαλώνουμε αλλά όχι απαραίτητα επειδή μεγαλώνουμε (τα ίδια σημάδια μπορεί να εμφανιστούν και στα 30). Η αλήθεια είναι ότι αυτά μπορεί να οφείλονται όχι μόνο στον χρόνο αλλά και/ή σε πολλούς άλλους παράγοντες», αναφέρει ο κ. Γεώργιος Α. Παπαγεωργίου, Πλαστικός Χειρουργός, Διδάκτωρ Πανεπιστημίου Αθηνών, Διπλωματούχος European Board of Plastic Reconstructive and Aesthetic Surgery (EBOPRAS), Μέλος της Ελληνικής Εταιρείας Πλαστικής Επανορθωτικής & Αισθητικής Χειρουργικής, της Ελληνικής Εταιρείας Μελανώματος και των διεθνών οργανισμών ISAPS & IPRES, και Διευθυντής Πλαστικής Χειρουργικής στο Metropolitan Hospital.
Παράγοντες που παίζουν ρόλο στην εμφάνιση των σημείων γήρανσης:
- Η γονιδιακή προδιάθεση του κάθε ατόμου
- Οι περιβαλλοντικές επιδράσεις
- Η έκθεση στην ηλιακή ακτινοβολία
- Η διατροφή από τα βρεφικά και παιδικά χρόνια
- Οι αυξομειώσεις βάρους
- Η χρήση αλκοόλ & διαφόρων άλλων ουσιών
- Το κάπνισμα.
Τρόποι αντιμετώπισης των σημαδιών της γήρανσης
Οι τρόποι αντιμετώπισης του φαινομένου της γήρανσης είναι η πρόληψη, οι συντηρητικές (μη επεμβατικές) και οι (πιο) επεμβατικές μέθοδοι.
Όμορφα πρόσωπα, χωρίς τα σημάδια του χρόνου
Είναι αποδεδειγμένο ότι οι άνθρωποι που προσέχουν τη διατροφή τους, που προστατεύονται από τον ήλιο, που αθλούνται και κοιμούνται σωστά, μεγαλώνουν διαφορετικά. Τα αποτελέσματα όμως αυτής της προσοχής είναι αθροιστικά, γι’ αυτό και ποτέ δεν είναι πολύ νωρίς για πρόληψη. «Ιδανικά η πρόληψη πρέπει να ξεκινάει από τη βρεφική/παιδική ηλικία υπό την επίβλεψη και την παρότρυνση των γονιών, έτσι ώστε στη συνέχεια να γίνει μια καλή συνήθεια που θα μας συντροφεύει και θα μας προστατεύει για όλη μας τη ζωή. Όσον αφορά τα σημάδια της γήρανσης (αλλά και ολόκληρο τον οργανισμό) είναι σημαντικό να:
- Προσέχουμε να μην εκτιθέμεθα ποτέ στον ήλιο χωρίς αντιηλιακή προστασία, καθώς ο ήλιος είναι μεν πηγή ζωής, αλλά ταυτόχρονα καταστρέφει όλους τους μηχανισμούς άμυνας και ανάπλασης του δέρματος μετά από παρατεταμένη έκθεση στην ακτινοβολία του.
- Προσέχουμε τη διατροφή μας. Η κακή διατροφή μαζί με την αυξομείωση βάρους, οδηγεί σε καταστροφικές συνέπειες για όλα τα όργανα του οργανισμού και φυσικά και για το δέρμα.
- Αποφεύγουμε το αλκοόλ και το κάπνισμα, καθώς και δύο αυτές συνήθειες από μόνες τους και ακόμα περισσότερο ο συνδυασμός τους, επιταχύνουν τη διαδικασία της γήρανσης με τη δημιουργία τοξικών βλαπτικών ουσιών.
Μη επεμβατικές μέθοδοι
1. Οι κρέμες προσφέρουν συνεχή ενυδάτωση της επιδερμίδας και την καθιστούν πιο ανθεκτική στους βλαπτικούς περιβαλλοντικούς παράγοντες.
2. Τα peeling κάθε είδους, από το απλό scrub έως τη χρήση μηχανημάτων μικροδερμοαπόξεσης και χημικού peeling, βοηθούν στην ανανέωση του δέρματος και την απομάκρυνση της κερατίνης στοιβάδας, με στόχο να εισχωρήσουν πιο εύκολα διάφορα προϊόντα της μεσοθεραπείας. Ένα σπουδαίο (και συχνά καθημερινό) peeling, για τους άνδρες, είναι το ξύρισμα.
3. Η μεσοθεραπεία ή βαθιά ενυδάτωση. Είναι μέθοδος κατά την οποία, με ενέσιμο τρόπο, αφού έχει τοποθετηθεί κρέμα για τοπική αναισθησία, εγχύονται ουσίες που προάγουν την παραγωγή κολλαγόνου και ελαστίνης φροντίζοντας παράλληλα να διατηρείται η υγρασία του δέρματος.
4. Το needling είναι μηχανικός ερεθισμός του δέρματος με ειδικά μηχανήματα (π.χ. dermapen) ή με rollers. Κατ’ αυτό, υπό τοπική αναισθησία με τοποθέτηση κρέμας, διατρυπάται η επιδερμίδα και έτσι διοχετεύονται στα βαθύτερα στρώματα του δέρματος θρεπτικές ουσίες, με στόχο την ανάπλαση.
5. Η χρήση laser και ραδιοσυχνοτήτων (RF), που είναι μορφές μη βλαπτικής ηλεκτρομαγνητικής ακτινοβολίας. Χρησιμοποιούνται για τη βελτίωση της ποιότητας, της υφής και της σύσφιγξης του δέρματος, καθώς επίσης και για την απομάκρυνση των καφέ κηλίδων ή των μικρών ευρυαγγειών, μέσω της διέγερσης παραγωγής κολλαγόνου και ελαστίνης από τους ινοβλάστες.
6. Ενέσιμα εμφυτεύματα
Ενέσιμο εμφύτευμα ονομάζεται το υλικό το οποίο μπορεί να έχει υγρή ή ζελατινώδη υφή. Είναι αποστειρωμένο και εγχύεται σε κάποια περιοχή του προσώπου ή του σώματος με σκοπό τη βελτίωση κάποιου εντυπώματος ή ρυτίδων. Το ενέσιμο εμφύτευμα πρέπει να είναι ασφαλές και να μην προκαλεί αλλεργικές αντιδράσεις. Σήμερα το ασφαλέστερο εμφύτευμα είναι το υαλουρονικό οξύ. Αξιόπιστα υλικά είναι επίσης η πολυκαπρολακτόνη (ellanse) και το πολυγαλακτικό οξύ (lanluma). Μεγάλη προσοχή απαιτείται κατά την εφαρμογή των υλικών στα χείλη. Γενικά όμως (και ειδικά στο πρόσωπο), όλες οι θεραπείες πρέπει να γίνονται σταδιακά, με πρόγραμμα, σχέδιο και υπομονή έτσι ώστε οι όποιες αλλαγές να συνειδητοποιούνται από τους ασθενείς.
Στα ενέσιμα εμφυτεύματα εντάσσεται και η θεραπεία με βοτουλινική τοξίνη (botox και dysport) για θεραπεία των ρυτίδων έκφρασης στο μεσόφρυο, στο μέτωπο, στη μύτη και «στο πόδι της χήνας» στο έξω μέρος των οφθαλμικών κόγχων, στο άνω και κάτω χείλος, καθώς και στο πηγούνι.
7. Αυτόλογη μεσοθεραπεία με πλάσμα πλούσιο σε αιμοπετάλια – PRP (Platelet Rich Plasma).
8. HIFU: Υψηλής έντασης στοχευμένος υπέρηχος, που προσφέρει σημαντική σύσφιγξη στο πρόσωπο και στον λαιμό σε αρχόμενη έως μέτρια χαλάρωση.
Αυτονόητο είναι ότι όλες οι παραπάνω μέθοδοι θα πρέπει να εξατομικεύονται, όπως επίσης και ότι δεν αντιμετωπίζονται μη επεμβατικά όλες τις περιπτώσεις.
Οι χειρουργικές επεμβάσεις, όπου κρίνεται αναγκαίο, δεν μπορούν να αντικατασταθούν από κανέναν άλλο τρόπο ή θεραπεία», επισημαίνει ο ιατρός.
Επεμβατικές μέθοδοι
Σε περιπτώσεις χαλάρωσης προσώπου και λαιμού, για να επιτευχθεί το επιθυμητό αποτέλεσμα χρειάζεται facelifting, σε συνδυασμό συνήθως με βλεφαροπλαστική. Άλλες επεμβάσεις που βελτιώνουν την εικόνα του προσώπου είναι η ρινοπλαστική και η ωτοπλαστική.
1. Facelifting
Το facelifting είναι μια εξατομικευμένη επέμβαση για την οποία συζητιούνται και αξιολογούνται οι ανάγκες του κάθε προσώπου ξεχωριστά, πριν την πραγματοποίησή της.
Με τη συγκεκριμένη επέμβαση δεν αλλοιώνονται τα χαρακτηριστικά του προσώπου, όπως λανθασμένα πιστεύουν αρκετοί άνθρωποι, βλέποντας κάποια παράξενα αποτελέσματα. Η ίδια η επέμβαση προσφέρει μόνον καλά και φυσικά αποτελέσματα, εφόσον αποφευχθούν οι υπερβολές και από τον ασθενή που πρέπει να έχει λογικές απαιτήσεις και από τον ιατρό που πρέπει να αποφύγει την οποιαδήποτε υπερδιόρθωση.
Δεν πρέπει ποτέ να «τραβηχτεί» υπερβολικά το δέρμα. Πρέπει απλώς να μετρηθεί σωστά πριν την εκτομή του. Η στήριξη του προσώπου γίνεται στους βαθύτερους και ισχυρότερους ιστούς, όπως είναι το επιφανειακό μυοαπονευρωτικό σύστημα (SMAS). Ο ασθενής, εάν είναι καπνίστρια/-ής, είναι καλό να έχει περιορίσει το τσιγάρο −εάν δεν μπορεί να το διακόψει−, έναν με δύο μήνες πριν την επέμβαση, αλλά και στο διάστημα της αποθεραπείας.
Σημαντικό για το αποτέλεσμα, είναι επίσης να φροντίζει κανείς ώστε η διατροφή του να είναι υγιεινή και ισορροπημένη και να μην έχει συχνές και μεγάλες αυξομειώσεις του βάρους του. Φυσικά, δεν νοείται lifting χωρίς τομές οι οποίες γίνονται σε σημεία που είναι λιγότερο ορατά.
Πώς γίνεται;
Οι τομές γίνονται εμπρός και πίσω από το αυτί καθώς και στο τριχωτό της κεφαλής χωρίς να κοπούν τα μαλλιά, αλλά εφαρμόζοντας ειδική διάταξη. Στον λαιμό, εάν η χαλάρωση είναι μεγάλη, μπορεί να χρειαστεί τομή στη φυσιολογική πτυχή που δημιουργείται αμέσως μετά το τελείωμα του πηγουνιού, μέσω της οποίας γίνεται η προσπέλαση της περιοχής, στην οποία μπορεί να εφαρμοσθεί, εάν κριθεί απαραίτητο, και λιποαναρρόφηση.
Η επέμβαση διαρκεί περίπου 4 ώρες. Ο ασθενής νοσηλεύεται για 1-2 ημέρες στο νοσοκομείο και φεύγει χωρίς κανέναν επίδεσμο και αφού έχουν λουστεί τα μαλλιά του. Τα ράμματα που χρησιμοποιούνται είναι πολύ λεπτά και αρχίζουν να αφαιρούνται σταδιακά από την έκτη μετεγχειρητική μέρα. Μετά την πρώτη εβδομάδα αρχίζει να υποχωρεί το οίδημα (πρήξιμο). Ο ασθενής μπορεί να κυκλοφορήσει πιο ελεύθερα μετά από 12 – 15 μέρες.
Θα πρέπει εδώ να επισημανθεί, ότι η επούλωση των τραυμάτων είναι διαφορετική από άνθρωπο σε άνθρωπο και από σημείο σε σημείο του προσώπου, αλλά και του σώματος.
Στη διάρκεια της αποθεραπείας το δέρμα χρειάζεται επιπλέον ενυδάτωση με κρέμες και προστασία από τον ήλιο. Με ένα πετυχημένο facelifting δημιουργείται μια τέλεια και μακράς διάρκειας υποδομή στο πρόσωπο. Η οποιαδήποτε θεραπεία εφαρμοστεί στη συνέχεια (peeling, ενέσιμα εμφυτεύματα, botox, κ.λπ.) θα έχει σαφώς πιο εντυπωσιακά αποτελέσματα.
2. Βλεφαροπλαστική
Η βλεφαροπλαστική, που μπορεί να πραγματοποιηθεί μεμονωμένα ή σε συνδυασμό με ένα facelifting, γίνεται για τη διόρθωση της χαλάρωσης του δέρματος των βλεφάρων και την αφαίρεση της περίσσειας του λίπους στην περιοχή των άνω & κάτω βλεφάρων.
Πώς γίνεται
Στο άνω βλέφαρο γίνεται μία τομή στο σημείο όπου φυσιολογικά δημιουργείται η πτυχή του. Στο κάτω βλέφαρο γίνεται τομή 1mm κάτω από το βλεφαρικό χείλος.
Υπάρχει και η προσπέλαση μέσω του βλεφαρικού επιπεφυκότος με τη χρήση laser. Η επέμβαση γίνεται με τοπική αναισθησία & μέθη ή στο πλαίσιο ενός facelifting με γενική αναισθησία. Παρουσιάζεται ήπιο οίδημα και μερικές φορές εκχυμώσεις (μελανιές). Δεν συνοδεύεται από πόνο. Τα ράμματα αφαιρούνται σε 4 ημέρες. Σε μια εβδομάδα ο ασθενής μπορεί να επιστρέψει στις δραστηριότητές του.
3. Ρινοπλαστική
Η ρινοπλαστική πραγματοποιείται όπου κρίνεται απαραίτητο για τη συμμετρία του προσώπου και μπορεί να συνδυαστεί με γενειοπλαστική, δηλαδή με τοποθέτηση προθέματος στο πηγούνι σε περιπτώσεις μικρού ή μετρίου υπογναθισμού της κάτω γνάθου. Η ρινοπλαστική είναι από τις πλέον σύνθετες και απαιτητικές επεμβάσεις της πλαστικής χειρουργικής. Είναι συνδυασμός γνώσης, εμπειρίας, τέχνης, ταλέντου, φαντασίας και κριτικής ικανότητας του πλαστικού χειρουργού. Γίνεται για την αισθητική διόρθωση του σχήματος και του μεγέθους της μύτης. Σε αρκετές περιπτώσεις, όταν φυσικά απαιτείται, συνοδεύεται και από λειτουργική διόρθωση, με σκοπό τη βελτίωση της αναπνοής (διόρθωση του ρινικού διαφράγματος και επέμβαση στις κάτω ρινικές κόγχες).
Πώς γίνεται
Πραγματοποιείται με γενική αναισθησία και η παραμονή στο νοσοκομείο είναι 1 ημέρα. Κατά το τέλος της επέμβασης, τοποθετούνται αιμοστατικά ταμπόν, που έχουν στο κέντρο μικρό σωληνάκι, έτσι ώστε να επιτρέπουν στον ασθενή να αναπνέει από τη μύτη κατά τις επόμενες 2-3 ημέρες που παραμένει με αυτά.
Στη ράχη της ρινός τοποθετούνται ειδικές αυτοκόλλητες ταινίες που προστατεύουν το δέρμα και παίζουν σημαντικότατο ρόλο στο «στρώσιμο» των μαλακών ιστών επάνω στον νεοδιαμορφωμένο σκελετό της. Τέλος, τοποθετείται ένας ειδικός θερμοπλαστικός νάρθηκας που στηρίζει για μία εβδομάδα τη μύτη. Ο ασθενής αισθάνεται «μπούκωμα» στη μύτη, έχει πρήξιμο, αλλά δεν έχει πόνο.
Μετά την εβδομάδα και την αφαίρεση του νάρθηκα τοποθετούνται νέες αυτοκόλλητες ταινίες για 5-7 επιπλέον ημέρες. Η μύτη συνεχίζει να ξεπρήζεται εμφανώς για το επόμενο μετεγχειρητικό δίμηνο. Στην ουσία όμως, η επούλωση συνεχίζεται για τους επόμενους οκτώ, δέκα ή δώδεκα μήνες.
4. Ωτοπλαστική
Με την ωτοπλαστική διορθώνονται περιπτώσεις αφεστώτων ώτων (πεταχτά αυτιά). Κατά τη συγκεκριμένη επέμβαση διορθώνονται επίσης η έλικα και η ανθέλικα των πτερυγίων των αυτιών, που, συνήθως, είναι ατελείς από τη γέννηση του ατόμου. Η ωτοπλαστική δύναται να πραγματοποιηθεί μετά την ηλικία των 6-7 ετών, και ιδανικά μετά τα 12 έτη, έτσι ώστε να υπάρχει καλύτερη επικοινωνία και συνεργασία με τον/την ασθενή.
Κάθε επέμβαση είναι μοναδική όσο και το κάθε άτομο που υποβάλλεται σ’ αυτήν
«Κάθε ασθενής είναι μοναδικός/ή και το ίδιο πρέπει να ισχύει και για την όποια επέμβαση θα κάνει. Στόχος επομένως του χειρουργού, που τίθεται σε συνεργασία με τον/την ασθενή, δεν είναι μόνο μια επιτυχής επέμβαση που θα αλλάξει όλη την εμφάνιση του προσώπου, θα ενισχύσει την αυτοπεποίθηση και παράλληλα θα επηρεάσει θετικά την ψυχολογία των ασθενών, βελτιώνοντας έτσι και την ποιότητα της ζωής τους. Είναι και η διαφύλαξη αυτής της μοναδικότητας του/της ασθενούς», καταλήγει ο κ. Παπαγεωργίου.
ΤΑ ΠΙΟ ΔΗΜΟΦΙΛΗ

ΔΙΑΒΑΖΟΝΤΑΙ ΠΑΝΤΑ
ΔΕΙΤΕ ΕΠΙΣΗΣ
Όταν η κούραση είναι κάτι περισσότερο από ανθρώπινη κατάσταση
Φυσικά η τεχνολογία δεν μπορεί να αντικαταστήσει την ανθρώπινη φροντίδα
Έρευνες δείχνουν ότι περίπου 1 στους 4 δεν εμφανίζει καθόλου συμπτώματα, ακόμη και μετά από βαριά κατανάλωση αλκοόλ
Η επαφή με το περιβάλλον μειώνει άμεσα το στρες, ρυθμίζει ορμόνες, ενισχύει το ανοσοποιητικό και βελτιώνει τη διάθεση
Οι τεχνικές που ηρεμούν το σώμα και τον νου όταν οι αρνητικές σκέψεις κυριαρχούν στην καθημερινότητα
Η κλινική δοκιμή περιέλαβε περισσότερους από 4.400 ασθενείς
Η δημοφιλής μέθοδος δροσιάς που τελικά χαλάει τον ύπνο - Πώς να τον χρησιμοποιήσετε σωστά
Eιδικοί εξηγούν γιατί το βάδισμα είναι το θεμέλιο της ευεξίας και πώς προστατεύει σώμα και πνεύμα
Επιστήμονες ανακάλυψαν ότι τα έντομα συνδέουν τη μυρωδιά του DEET με την τροφή, ανατρέποντας όσα ξέραμε
Με επίκεντρο το μέλλον της ογκολογικής φροντίδας
Τα συμπτώματα και η διάγνωση
Βλεφαρίτιδα, μία χρόνια φλεγμονή του βλεφαρικού χείλους
Μερικές φορές η δυσκολία δεν είναι εμπόδιο, αλλά απαραίτητη προϋπόθεση για συνεχή εξέλιξη
Οι ειδικοί σημειώνουν ότι ορισμένοι γαλακτωματοποιητές ενδέχεται να επηρεάζουν αρνητικά το έντερο
Ο ΕΟΔΥ προειδοποιεί για επανεμφάνιση κρουσμάτων και αυξημένο κίνδυνο στους ηλικιωμένους
Συμμετείχαν ενεργά στην υλοποίηση 11 οργανωμένων εθελοντικών δράσεων
Με αφορμή την Παγκόσμια Ημέρα κατά του Καπνίσματος στις 31/5
Παγκόσμια Ημέρα Υγείας της Έμμηνου Ρύσης 28 Μαΐου
Ο γιατρός και ερευνητής μιλά για τη διαδρομή του στην έρευνα, τη φύση της επιστήμης και τις μεγάλες προκλήσεις της σύγχρονης ιατρικής
Έχετε δει 20 από 200 άρθρα.